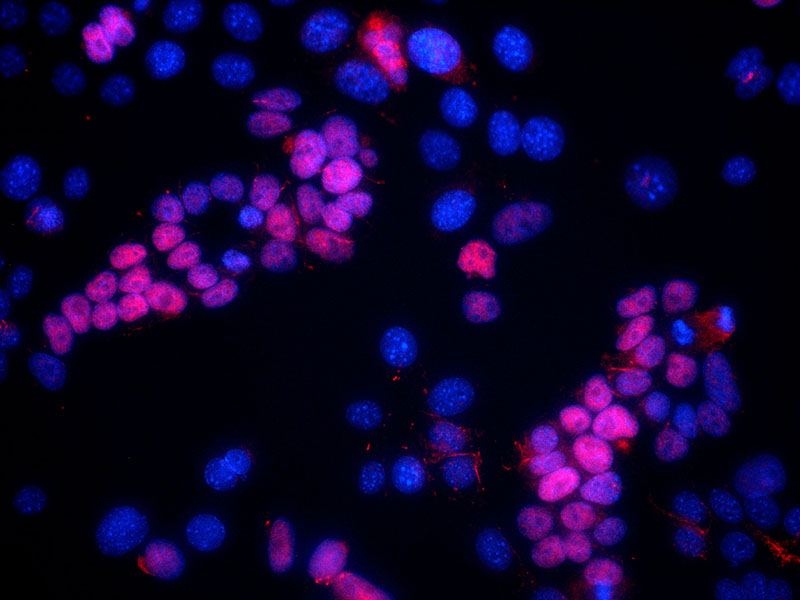
IF result of anti-SIX1(1:50) in p53-/- mammary epithelial tumor cells. Blue: hoechst nuclear stain, Red: SIX1 stain the mesenchymal cell which have undergone EMT.

-
Product Name
SIX1 antibody
- Documents
-
Description
SIX1 Rabbit Polyclonal antibody. Positive IF detected in epithelial tumor cells. Positive IP detected in HEK-293 cells. Positive WB detected in A2780 cells, HEK-293 cells, HepG2 cells, L02 cells, PC-3 cells, SKOV-3 cells. Observed molecular weight by Western-blot: 32-40 kDa
-
Tested applications
ELISA, WB, IF, IP
-
Species reactivity
Human, Mouse; other species not tested.
-
Alternative names
BOS3 antibody; DFNA23 antibody; Homeobox protein SIX1 antibody; Sine OCulis homeobox homolog 1 antibody; SIX homeobox 1 antibody; SIX1 antibody; TIP39 antibody
-
Isotype
Rabbit IgG
-
Preparation
This antibody was obtained by immunization of SIX1 recombinant protein (Accession Number: NM_005982). Purification method: Antigen affinity purified.
-
Clonality
Polyclonal
-
Formulation
PBS with 0.1% sodium azide and 50% glycerol pH 7.3.
-
Storage instructions
Store at -20℃. DO NOT ALIQUOT
-
Applications
Recommended Dilution:
WB: 1:200-1:2000
IP: 1:500-1:5000
IF: 1:20-1:200
-
Validations

A2780 cells were subjected to SDS PAGE followed by western blot with Catalog No:115249(SIX1 antibody) at dilution of 1:800
IF result of anti-SIX1(1:50) in p53-/- mammary epithelial tumor cells. Blue: hoechst nuclear stain, Red: SIX1 stain the mesenchymal cell which have undergone EMT.

IP Result of anti-SIX1 (IP:Catalog No:115249, 3ug; Detection:Catalog No:115249 1:1000) with HEK-293 cells lysate 2560ug.
-
Background
SIX1 belongs to SIX family that contains a divergent DNA-binding homeodomain and an upstream SIX domain, which may participate both in determining DNA-binding specificity and in mediating protein-protein interactions. It may be involved in limb tendon and ligament development, and specifically expressed in skeletal muscle. SIX1 plays a essential role in the development of numerous organs and shows littlt to no expression in most non-neoplastic adult tissue, yet is overexpression in a number of meoplasms where it increases cell proliferation and survival.
-
References
- Suzuki Y, Ikeda K, Kawakami K. Expression of Six1 and Six4 in mouse taste buds. Journal of molecular histology. 41(4-5):205-14. 2010.
- Liu D, Zhang XX, Wan DY. Sine oculis homeobox homolog 1 promotes α5β1-mediated invasive migration and metastasis of cervical cancer cells. Biochemical and biophysical research communications. 446(2):549-54. 2014.
- Adrados I, Larrasa-Alonso J, Galarreta A. The homeoprotein SIX1 controls cellular senescence through the regulation of p16INK4A and differentiation-related genes. Oncogene. 2015.
Related Products / Services
Please note: All products are "FOR RESEARCH USE ONLY AND ARE NOT INTENDED FOR DIAGNOSTIC OR THERAPEUTIC USE"
